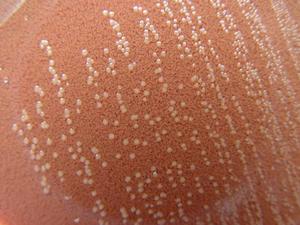
頭孢沙定

作用機制
電鏡下的細菌
電鏡下的細菌頭孢沙定作用機制與其它頭孢菌素類藥相似,是通過抑制細菌細胞壁的生物合成而起殺菌作用。抗菌譜:頭孢沙定對葡萄球菌屬、溶血性鏈球菌、肺炎球菌、大腸桿菌、流感桿菌、克雷白桿菌屬、奇異變性桿菌等有良好的抗菌作用。
藥動學
頭孢沙定口服後經消化道迅速吸收,空腹口服1g後,45分鐘可達血藥峰濃度,約為26.5μg/mL。藥物吸收後可向痰液、扁桃體組織等分布,乳汁中濃度較低。本品主要經腎以原型隨尿液排泄,半衰期為2-3小時。腎功能障礙者半衰期延長。
適應症
 頭孢沙定可用於扁桃體發炎
頭孢沙定可用於扁桃體發炎頭孢沙定臨床上可用於敏感菌所致的下列感染:
1、呼吸系統感染,如支氣管炎、咽喉炎、扁桃體炎等。2、泌尿系統感染,如膀胱炎等。
3、皮膚、軟組織感染,如癤、癰、毛囊炎、蜂窩組織炎等。
4、猩紅熱。
注意事項
 血紅蛋白結構圖
血紅蛋白結構圖1.禁忌症:對頭孢沙定或其它頭孢菌素類藥過敏者禁用。
2.慎用:(1)嚴重腎功障礙患者慎用。(2)高度過敏性體質或家族有過敏史者慎用。(3)高齡體弱患者、全身狀況差者慎用。3.藥物對檢驗值或診斷的影響:少數患者用藥後可出現轉氨酶升高,白細胞總數、紅細胞、血紅蛋白減少,嗜酸粒細胞增多等。
4.用藥前後及用藥時應當檢查或監測的項目:長期用藥時應常規監測肝、腎功能和血象。
不良反應
1.用藥後可見皮疹、蕁麻疹、紅斑、瘙癢、發熱、淋巴管腫脹等過敏反應,偶見過敏性休克。
2.用藥後可見噁心、嘔吐、食慾減退等胃腸道反應,偶見偽膜性腸炎(伴有發熱、腹痛、白細胞增多和粘液血便的劇烈腹瀉)。3.少數患者用藥後可出現肝酶一過性升高。
4.有報導長期用藥後可發生菌群交替,出現口炎、念珠菌病等。
5.有報導長期用藥後可發生維生素K、維生素B缺乏症。
藥物相互作用
1.頭孢沙定與其它頭孢菌素合用可增加腎毒性。
2.頭孢沙定與氨基糖苷類抗生素類藥合用可增加腎毒性。
3.頭孢沙定與呋塞米等強利尿劑合用可增加腎毒性。
給藥說明
 苯
苯1.頭孢沙定僅供口服給藥,且宜飯後服用。
2.在用藥過程中如發生過敏反應、眩暈、耳鳴或嚴重腹痛、腹瀉時應立即中止給藥。
用法與用量
成人口服給藥:1.一般感染,每次250-500mg,每日3-4次,飯後服用。2.皮膚感染,每次250mg,每日2次,飯後服用。
兒童口服給藥:乾糖漿口服液,每日按30mg/kg,分三次服用。
常用製劑與規格
1、頭孢沙定膠囊250mg。
2、頭孢沙定乾糖漿每克含頭孢沙定100mg。
合理套用
 消化道
消化道1、頭孢沙定僅僅對細菌感染有治療作用,對病毒、支原體、衣原體、真菌(黴菌)等引起的感染無治療作用。只有當臨床確診為細菌感染,如血液中白細胞明顯增多伴中性粒細胞比值升高,套用頭孢沙定才能發揮治療作用。
 靶細胞
靶細胞3、第三代頭孢沙定是在醫院內套用最多的頭孢沙定,根據其殺滅革蘭陰性桿菌的特點分為兩類。一類以殺滅腸桿菌科細菌如大腸桿菌、變形桿菌、克雷伯桿菌為主,亦有殺滅革蘭陽性菌的作用,常用的有頭孢三嗪(頭孢曲松,又稱為菌必治)、頭孢噻肟、頭孢地嗪等;另一類以殺滅銅綠假單胞菌(又稱綠膿桿菌)為主,亦包括其他革蘭陰性桿菌,常用的有頭孢哌酮和頭孢他啶。
4、頭孢沙定根據其代謝和排泄途徑分為肝腸排泄和腎臟排泄藥物。例如臨床常用的頭孢哌酮經肝腸排泄,對膽道和腸道細菌感染治療作用明顯;頭孢他啶經腎臟尿液排泄,對尿路細菌感染治療作用較強。經肝腸排泄的藥物對肝功能有影響,肝功能異常和膽道阻塞時不宜使用;肝腸排泄的藥物影響腸道正常細菌的生存,常導致維生素B和K的吸收減少和腸道菌群紊亂而引起腹瀉,用藥時應注意預防。經腎臟排泄的藥物對腎臟有一定的損傷,尤其以第一代頭孢沙定為明顯,腎功能不全時就慎用或減量使用;同時應避免與其他影響腎臟的藥物如呋噻咪等同時使用。頭孢三嗪同時經肝臟和腎臟雙途徑排泄,臨床用藥的安全性較高。
 青黴素
青黴素6、兩種品種的頭孢沙定不宜同時使用,亦不宜與青黴素合用。同類藥物的合用可造成毒副作用增加。多種細菌混合感染時可選用抗菌譜較廣的頭孢沙定;與其他抗菌藥物同用時應分別給藥,注意避免與氨基糖類藥物混合或同時注射。
7、細菌對頭孢沙定產生耐藥性主要與細菌產生的能水解頭孢沙定的β內醯胺酶有關。聯合使用抑制β內醯胺酶的藥物,如舒巴坦、三唑巴坦或克拉維酸,可提高臨床療效。
 葡萄糖
葡萄糖9、注射用頭孢沙定配藥時應注意溶解後儘快使用,配好的藥液室溫下放置不宜超過5小時,冰櫃4℃保存不宜超過12-24小時。配置藥液多為1%-2%的濃度,常用2g藥粉加入生理鹽水或5%葡萄糖液100ml,於1-2小時輸完,避免因藥液濃度過高對靜脈血管刺激和藥液過多滴注時間過長致藥效降低。
致過敏休克案例
頭孢沙定是一種活性廣譜抗生素,主要用於治療革蘭陽性菌感染,由於無需作皮試,抗菌效果尚可,臨床使用較受歡迎。現將該藥致過敏性休克1例報告如下。
病歷摘要
 維生素B6
維生素B6專家討論
頭孢沙定屬大環內酯類廣譜抗生素,過敏發生率極低,目前尚未見報導過,由於本藥屬廣譜抗生素,無需做過敏試驗,患者易接受,臨床使用方便,且範圍較廣,此例過敏機制尚不詳,但為我們廣大臨床醫務工作者敲響了警鐘。用藥需慎重,不要因為過敏發生率低,使用方便,而忽略了對患者的危害。因此臨床使用時應注意患者的個體差異及對藥物的敏感性,應嚴密觀察。
 腎上腺
腎上腺患者xx,男,37歲,住院號39964,因頭部被釘錘擊傷後流血,在門診行傷口清創縫合後入院。當時有短暫昏迷史。清醒後感頭部疼痛、流血,無大小便失禁,無四肢抽搐。
入院後,給予抗感染對症治療,輸0.9%氯化鈉250ml加頭孢沙定2g靜脈滴注,皮試為陰性。前二天輸入後患者無任何不良反應,但在第三天液體輸入到150ml時,患者出現頭部劇痛,四肢發抖,測體溫38.1℃。
當時靜脈滴注,非那根25mg肌肉注射,急查心電圖提示竇性心動過速,經過上述處理病情仍無緩解,並且患者出現胸悶、胸痛,口周麻木,舌頭髮僵,活動困難,大小便失禁,神志不清,血壓逐漸下降至70/40mmHg,考慮為藥物過敏性休克。立即皮下注射鹽酸腎上腺素1ml,輸入10%葡萄糖100ml,多巴胺40mg,使血壓維持在100/70mmHg,經過4個小時的抗休克、抗過敏治療及處理,患者神志清楚,頭痛、四肢發抖、胸悶、胸痛、舌頭髮僵等症狀消失,血壓回升在100-130/90-70mmHg,面色紅潤,7天后痊癒出院。
討論
頭孢沙定經皮試為陰性後,極少發生過敏反應。本例患者出現過敏的原因可能與變應原有關。
 線粒體
線粒體藥物的過敏反應對人體危害大,且發病率高,輕則產生藥疹,重則發生過敏性休克,過敏性休克是一種發生快、危害極嚴重的變態反應,稍有不慎,會給患者造成很大的痛苦,甚至危及生命。如果發現、搶救不及時,患者可因過敏性休克而迅速死亡。所以在臨床工作中,我們除了操作前應做好急救的準備工作(備好鹽酸腎上腺素和注射器)外,還應詳細詢問病人的用藥史、過敏史和家族過敏史。即使皮試為陰性,也不可麻痹大意,在用藥的過程中嚴密觀察病人,注意局部和全身反應,傾聽病人主訴,詢問有何不適,及時發現細微變化,防患於未然。
 血管
血管膀胱炎治療
慢性膀胱炎常伴有結石、畸形或其它梗阻因素,為非單純性膀胱炎。因此,慢性膀胱炎治療的首要問題是糾正尿路的複雜因素。尿路複雜因素糾正後可予以較長時間的抗菌療法,具體內容可參考慢性腎盂腎炎的治療。有人建議,患慢性膀胱炎時要配合局部治療,可採用抗菌膀胱灌洗術。常用的灌洗液是生理鹽水100mL內含1∶20000頭孢沙定或1%呋喃西林或40萬單位慶大黴素,將灌洗液灌入膀胱內,留置30分鐘後放出,如此反覆4~6次。灌洗後可灌注5%弱蛋白銀30mL及2%奴佛卡因2mL以保護膀胱黏膜。急性膀胱炎的患者,首先需要臥床休息,多飲水,避免刺激性食物,熱水坐浴可改善會陰部血液循環,減輕症狀。碳酸氫鈉或頭孢沙定等鹼性藥物,能降低尿液酸度,緩解膀胱痙攣,頭孢沙定可解除痙攣,減輕尿路刺激症狀。傳統的10~14日的抗菌療法對無併發症的膀胱炎並無必要,國內外提倡單次大劑量或3日短療程治療。
 甲潑尼龍
甲潑尼龍為了徹底滅菌,有作者認為其常規療程仍以3天為宜。複方新諾明2片,頭孢沙定2.0g,每日2次;或羥氨苄青黴素0.5g,每日4次;氟嗪酸0.2g,每日2次。均連續服用3天,對膀胱炎的治癒率與傳統的14日療法相似,且副作用少。其適應症與禁忌症同單程療法。至於老年人的下尿路感染,Mccne認為:老年人不論是症狀性或無症狀性,都應採用5~7天療程,因為老年人多存在膀胱功能異常,膀胱流出道不全梗阻及陰道、尿道黏膜萎縮等,使治療增加困難。
單劑療法和3日療法避免了不必要的長期服藥而產生的耐藥細菌和副作用的增加,但要加強預防復發的措施。若症狀不消失,尿膿細胞繼續存在,細菌培養仍為陽性,應考慮細菌耐藥或有感染的誘因,要及時調整更適合的抗菌藥物,延長套用時間以期達到早日治癒的目的。對於久治不愈或反覆發作的慢性膀胱炎,要做詳細全面的泌尿系檢查,要解除梗阻因素,控制原發病灶,使尿路通暢。對神經系統疾患所引起的尿瀦留和膀胱炎,根據其功能障礙類型進行治療。
